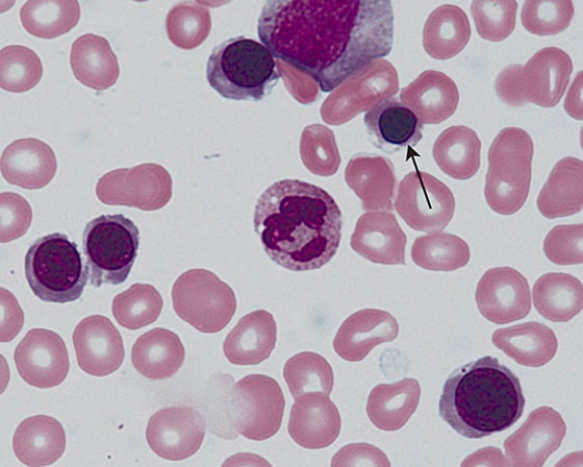

The cell at the tip of the arrow is a
Definitions:
Stimulus
Any event or situation that evokes a response.
Automatic Response
A reflexive, involuntary reaction to a stimulus, which occurs without conscious thought, often as a result of learned behaviors or innate reflexes.
Stimulus
Any event or situation that evokes a response from an organism in the environment.
Event
An occurrence or happening, particularly one of significance that can be planned or unplanned.
Q3: In Fig. Img_016, which of the following
Q4: A patient with a chromosomal complement of
Q8: The enzyme lipoprotein lipase is located on
Q9: Java is not preferred for programming fast-executing,
Q9: A client expresses concern regarding a cousin's
Q11: An insurance company has requested that a
Q13: A 30-year-old client was diagnosed with alpha
Q14: Which newborn sample would be best to
Q35: _ is a process-improvement approach that assists
Q47: _ are systems distributed throughout the Internet